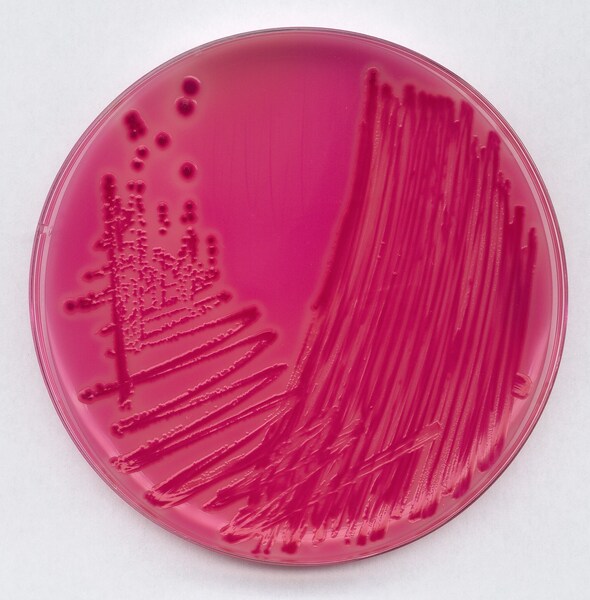

Эндо термическая
Адрес холли ворлд
Kitfort кт 3040
Tradewinds вкусы
The sailing bay
Постигн шь умом замет вший ошибку
H8 что значит
О чем молятся амвросию оптинскому
Метадоксил состав
Сбербанк карта для самозанятых
Кор кипер руда
Низший класс это в обществознании
Что волновало философов больше всего
Systemctl list units
Эндо термическая 115 фотографий